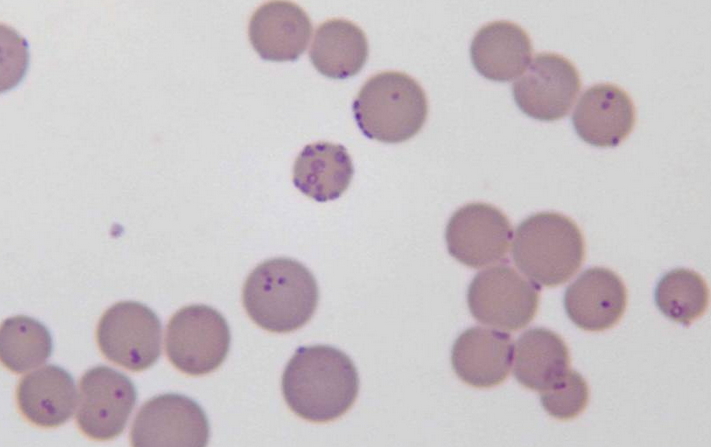

Avec ses 200 nanomètres, la bactérie mycoplasme est sans conteste la forme de vie la plus petite connue par l’homme. Il faut également savoir que plus d’une centaine d’espèces composent ce genre. Certaines sont d’ailleurs responsables de maladies chez les humains.
Les chercheurs désignent un organisme vivant après avoir établi trois caractéristiques essentielles, à savoir sa capacité à se développer (assembler ses composants basiques), se reproduire (à l’aide de ses propres ressources) et bénéficier d’une limitation entre son intérieur et l’environnement extérieur.
Interrogé par Science & Vie, le virologiste de l’Institut de microbiologie de la Méditerranée Jean-Michel Claverie explique que « pour présenter ces différentes propriétés, un organisme doit contenir une membrane qui le délimite, un génome, l’ensemble des enzymes lui permettant de répliquer ce génome et une machine moléculaire pour fabriquer des protéines. »
Ainsi, tout l’attirail que doit détenir un organisme vivant pour être considéré comme tel prend une certaine place et donc une taille minimum. Il y a quelques années, le biochimiste belge Christian de Duve avait fixé cette limite de taille à 200 nanomètres, soit 0,2 millionième de mètre, caractérisée néanmoins par une absence de paroi cellulaire. Il s’agit d’une taille minimum pour contenir l’intégralité des éléments évoqués plus haut et correspondant exactement à celle de la bactérie mycoplasme (ou mycoplasma)
Déclinée en plus d’une centaine d’espèces, la bactérie mycoplasme peut engendrer diverses maladies chez l’être humain. Citons par exemple Mycoplasma pneumoniae (infections respiratoires) ou encore Mycoplasma genitalium et Mycoplasma hominis causant des infections génitales.
Les experts en exobiologie indiquent tout de même l’existence de « réplicateurs », des organismes (avec ou sans paroi cellulaire) simplement composés d’ensembles de molécules, capables de s’auto-organiser et de se reproduire en absorbant l’énergie de leur milieu. Cette forme de vie très simple se trouve donc à l’échelle moléculaire (0,1 nm).
Sources : Science & Vie – Docteur Clic